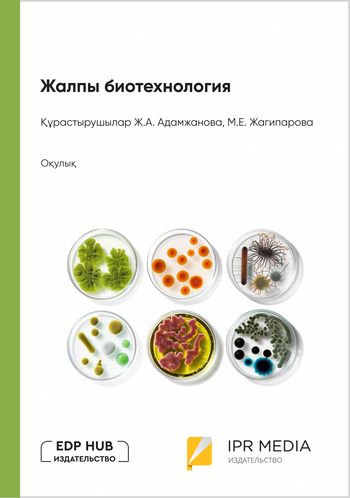

Жалпы биотехнология. Оқулық
Об издании
Бұл оқулық өндірісте тірі организмдер мен биологиялық процестерді қолдануға арналған; экономикалық құнды заттарды алу үшін гендік және жасушалық деңгейде өзгертілген биологиялық объектілерді жобалау технологиялары мен қолданылуы. Оқулық «Жалпы биотехнология» пәнін оқитын биотехнологиялық оқу орындарының магистранттары мен студенттеріне арналған.
Библиографическая запись
Жалпы биотехнология : оқулық / . — Алматы, Москва : EDP Hub (Идипи Хаб), Ай Пи Ар Медиа, 2024. — 332 c. — ISBN 978-5-4497-3629-1. — Текст : электронный // Цифровой образовательный ресурс IPR SMART : [сайт]. — URL: https://www.iprbookshop.ru/142873.html (дата обращения: 18.02.2026). — Режим доступа: для авторизир. пользователей
РЕКОМЕНДУЕМ К ПРОЧТЕНИЮ
Максимов Г.В., Василенко В.Н., Клименко А.И., Максимов А.Г., Ленкова Н.В.
(Профобразование, Ай Пи Ар Медиа)
Голикова А.Н.
(EDP Hub (Идипи Хаб), Ай Пи Ар Медиа)
Голикова А.Н.
(EDP Hub (Идипи Хаб), Профобразование)
Байкенжина К.А.
(EDP Hub (Идипи Хаб), Профобразование)
Әділбеков М.Ә., Әбдікәрімов С.Ә., Калиев Б.З.
(EDP Hub (Идипи Хаб), Ай Пи Ар Медиа)
C ЭТОЙ КНИГОЙ ТАКЖЕ ЧИТАЮТ
Леу А.Г., Алексеев Г.В., Литвяк В.В.
(Ай Пи Ар Медиа)
Белошапкина О.О., Ганнибал Ф.Б., Тараканов Р.И., Чебаненко С.И., Джалилов Ф.С.-У.
(Ай Пи Ар Медиа)
Сычева О.В., Шлыков С.Н., Скорбина Е.А., Трубина И.А., Омаров Р.С.
(АГРУС)
Омаров Р.С., Шлыков С.Н., Сычева О.В., Скорбина Е.А., Трубина И.А.
(АГРУС)
Плохих Ю.В., Храпова Е.В., Кулик Н.А., Чижик В.П., Харина Л.И.
(Ай Пи Ар Медиа)
Ухарцева И.Ю., Гольдаде В.А., Цветкова Е.А., Шаповалов В.М.
(Белорусская наука)
Гумеров Т.Ю., Габдукаева Л.З., Решетник О.А.
(Издательство КНИТУ)

.jpg)
.jpg)












